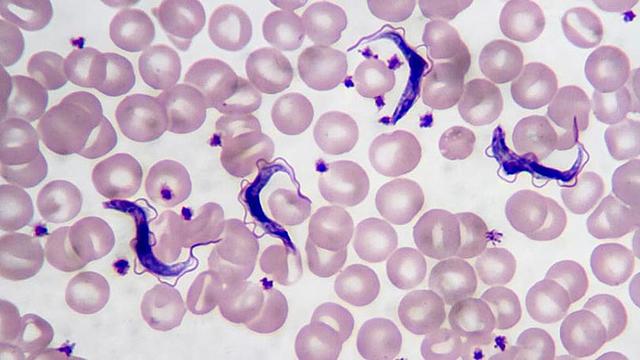
Descubrimiento del tripanosoma

-
Antonio van Leeuwenhoek, considerado como el padre de la microbiología, nace en 1632, en Delft, Holanda.
-
El médico y anatomista neerlandés Regnier de Graaf es quien presenta las primeras observaciones de van Leeuwenhoek a la Royal Society en 1673.
-
En una carta fechada el 7 de septiembre de 1674, evoca por primera vez las minúsculas formas de vida que observó en las aguas de un lago cerca de Delft.
-
Robert Hooke, afirma la realidad de las observaciones sobre microorganismos de van Leeuwenhoek en la sesión del 15 de noviembre de 1677 de la Royal Society.
-
En 1677, mencionó por primera vez los espermatozoides, en una carta enviada a la Royal Society, en la que habla de animálculos, muy numerosos en el esperma.
-
Murió el 26 de agosto de 1723 en Delft, a los 90 años. Durante su vida fabricó más de 500 lentes.
-
Nace Lazzaro Spallanzani en 1729, en Scandiano, un pueblo del norte de Italia.
-
En 1769, tras rechazar la teoría de la generación espontánea, Spallanzani diseñó experimentos para refutar los realizados por John Needham, prolongando el periodo de calentamiento y sellando con más cuidado los recipientes, Spallanzani pudo demostrar que dichos caldos no generaban microorganismos mientras los recipientes estuvieran sellados.
-
Fallece el sacerdote y naturalista Spallanzani en 1799, en Pavía.
-
Nace Louis Pasteur, considerado el padre de la microbiología moderna, en Dole, Francia el 27 de diciembre de 1822.
-
Robert Koch nació el 11 de diciembre de 1843, en Clausthal en las montañas del Harz, considerado el padre de la microbiología médica moderna.
-
En 1848, Pasteur resolvió el misterio del ácido tartárico. Mientras una forma polarizaba la luz a la derecha, la otra la polarizaba a la izquierda, una era dextrógira y otra levógira.
-
En 1857 Pasteur descubre la fermentación láctica: descubrimiento de la bacteria que la produce.
-
En 1860, Pasteur estudia la fermentación butírica: carácter anaerobio de sus agentes.
-
En 1870, Pasteur estudia el problema del gusano de la seda: descubre los agentes de la enfermedad y descubre el modo de evitarlas.
-
En 1876, Pasteur estudia la fermentación alcohólica, invención de la pasteurización para evitar «las enfermedades del vino «y de la cerveza.
-
Robert Koch fue el primero en demostrar definitivamente, mediante experimentos científicos, que una enfermedad específica (el carbunco o ántrax) fue causada por un microorganismo específico. Publicó sus descubrimientos en 1876
-
En 1877, Pasteur estudia el carbunco: trabajando en el control de la enfermedad (carbonosa) conocida como enfermedad de los «campos malditos de Beauce»; investiga y desarrolla una vacuna contra este flagelo.
-
Pasteur experimentó con perros provocandoles la rabia ya que en su epoca, esta enfermedad era muy temida en la sociedad, para poder avanzar en su investigacion de la causa de los sintomas de la rabia, su ayudante Roux, hizo una prueba a escondidas de Pasteur y esperando sintomas pasando las semanas se dieron cuenta que se habia curado un perro habiendole inyectado dosis virulentas atenuadas. "Murió un perro para salvar miles de personas"
-
PABLO EHRLICH mejoró el empleo del azul de metileno como colorante bacteriológico
-
Robert Koch se hizo famoso por descubrir el bacilo de la tuberculosis en 1882.
-
Pablo Ehrlich comunicó que la fiebre tifoidea puede diagnosticarse mediante la diazorreacción al demostrar el urobilinógeno en la orina
-
PABLO EHRLICH demostró, dentro de sus estudios con tinciones vitales muy importantes en el desarrollo de su concepto de la quimioterapia, la afinidad del azul de metileno por las terminaciones del sistema nervioso
-
El niño Joseph Meister habia sido atacado gravemente por un perro rabioso, y su madre desesperada fue al laboratorio de Pasteur para que lo curara. Con dos medicos iniciaron el proceso de inmunizacion soportando la inyeccion de los virus atenuados jamas presentó sintomas de rabia.
-
David Bruce descubrió el organismo que causa la fiebre de Malta y demostró que los seres humanos contraían esta enfermedad al beber la leche de ganado enfermo. Dicho organismo era la Brucella, grupo de cocos y bacilos gram-negativos de las que cuatro especies son patógenas para los humanos.
-
Descubrió que el bacilo de la difteria destila un veneno extraño y que un gramo de esa sustancia bastaba para producir la muerte a 250 perros. El experimentaba con muchos conejos y conejillos de indias.
-
Roux y especialmente Behring experimentaban con conejillos de indias para buscar una antitoxina de la difteria que atormentaba la salud de los niños de la epoca, entonces les inyectaba la toxina de la difteria y despues sustancias quimicas, como tricloruro de yodo, siendo esta una cura poco duradera contra la enfermedad
-
Theobald Smith descubrió que la fiebre bovina de Texas era causada por la Babesia bigemina, un protozoo que, era transmitido por las garrapatas.
-
Dió la explicación de por qué el ganado vacuno del norte cuando es trasladado al sur se enferma y muere de fiebre de texas. Y descubrio que es debido a una garrapata de la región que les chupaba la sangre al ganado, pero descubrio que solo lo hacia la garrapata joven.
-
El padre de la inmunología. Durante una epidemia de cólera, Metchnikoff fue su propio conejillo de indias e ingirió una bebida con el virus Vibrio cholerae con el fin de probar su teoría de que el sistema inmune hacía que algunas personas resistieran ciertas infecciones.
-
Theobald Smith realizó la distinción entre el bacilo de la tuberculosis humano y el bovino.
-
David Bruce mientras estudiaba en Sudáfrica una enfermedad del ganado llamada nagana descubrió el tripanosoma, un tipo de microbio, que era el causante de la enfermedad del sueño en el hombre.
-
ROSS CONTRA GRASSI expuso sus iniciales convicciones sobre el papel del mosquito Anopheles en la transmisión de la enfermedad. Las investigaciones orientadas al conocimiento del agente causal del paludismo
-
Walter Reed llegó a determinar mediante experimentos que el agente causante de la fiebre amarilla era el mosquito Aedes aegypti.
-
David Bruce fue miembro de una comisión en Sudáfrica que investigó los orígenes de la disentería en este campo y su relación con la fiebre entérica.
-
PABLO EHRLICH realizó una preparación de arsénico orgánico empleada en el tratamiento de la sífilis y de la fiebre recurrente, y del neosalvarsán (neoarsfenamina). Logró eliminar así a los gérmenes causantes de enfermedad sin lesionar al organismo mediante la inyección de un producto en la sangre. Este conjunto de trabajos significó su gloria y el comienzo de una fase revolucionaria para la farmacología y, por tanto, para la terapéutica.
-
Bruce y su esposa demostraron que la enfermedad el sueño se transmite de los animales al hombre y de una persona a otra por medio de la mosca tsetsé.
-
Robert Koch recibió el Premio Nobel de Medicina en 1905 por sus trabajos sobre la tuberculosis.
-
Obtiene el premio Nobel de Fisiología y Medicina, compartido con Élie Metchnikoff, en reconocimiento por sus trabajos sobre inmunidad.
-
Theobald Smith describió la presencia de brucellas en el protoplasma de las células del epitelio corial, en la placenta bovina. También señaló que algunas estaban totalmente llenas de parásitos y encontró histiocitos adventiciales con gérmenes, aventurando la idea de que había multiplicación intracelular, lo que no se verificó hasta pasados muchos años.
-
La incidencia de la fiebre amarilla ha descendido drásticamente en todo el mundo gracias a la aplicación del descubrimiento de Reed. Dentro de pocos años no quedará sobre la tierra la menor traza del virus.
Looking for a timeline maker?
Create timelines for projects, roadmaps, history, lessons, legal cases, and stories with Timetoast. Timetoast is a timeline maker for work, school, research, and stories.